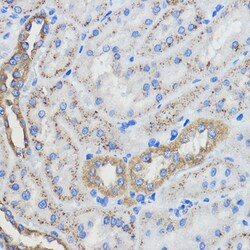
Invitrogen CYP51A1 Polyclonal Antibody 100 &mu;L; Unconjugated:Anticuerpos

missing translation for 'onlineSavingsMsg'
Learn More
Learn More
Invitrogen™ CYP51A1 Polyclonal Antibody
Rabbit Polyclonal Antibody
Marca: Invitrogen™ PA576873
Este artículo no se puede devolver.
Vea la política de devoluciones
Descripción
The antibody was affinity-purified from rabbit antiserum by affinity-chromatography using epitope-specific immunogen and the purity is > 95% (by SDS-PAGE).
P450 enzymes constitute a family of monooxygenase enzymes that are involved in the metabolism of a wide array of endogenous and xenobiotic compounds. Several P450 enzymes have been classified by sequence similarities as members of the CYP1A and CYP2A subfamilies. CYP51A1 (cytochrome P450, family 51, subfamily A, polypeptide 1), also known as LDM (lanosterol 14-alpha demethylase) or cytochrome P450-14DM, is a 503 amino acid protein localized to endoplasmic reticulum membrane. CYP51A1 is an important enzyme for zymosterol and steroid biosynthesis. CYP51A1 catalyzes C14-demethylation of lanosterol, transforming lanosterol into 4,4'-dimethyl cholesta-8,14,24-triene-3-beta-ol. CYP51A1 is ubiquitously expressed, with highest levels found in liver, ovary, testis, lung, kidney and prostate.
Especificaciones
| CYP51A1 | |
| Polyclonal | |
| Unconjugated | |
| CYP51A1 | |
| AI426508; CP51; CYP51; CYP51A1; CYPL1; CYPLI; Cytochrom P450 Lanosterol 14 alpha-demethylase; Cytochrome P450 51; cytochrome P450 51A1; cytochrome P450 family 51 subfamily A member 1; cytochrome P450 Lanosterol 14 alpha-demethylase; cytochrome P450, 51; cytochrome P450, 51 (lanosterol 14-alpha-demethylase); cytochrome P450, family 51; cytochrome P450, family 51, subfamily A, polypeptide 1; cytochrome P450, subfamily 51; Cytochrome P45014DM; cytochrome P450-14DM; cytochrome P450LI; Lanosterol 14-alpha demethylase; lanosterol 14-alpha-demethylase; LDM; P450 14DM; P45014DM; P450-14DM; P450L1; P450LI; RATCP14DM; Sterol 14-alpha demethylase | |
| Rabbit | |
| Antigen affinity chromatography | |
| RUO | |
| 13121, 1595, 25427 | |
| Store at 4°C short term. For long term storage, store at -20°C, avoiding freeze/thaw cycles. | |
| Liquid |
| Immunohistochemistry (Paraffin), Western Blot, Immunocytochemistry | |
| 1 mg/mL | |
| PBS with 50% glycerol and 0.02% sodium azide; pH 7.2 | |
| Q16850, Q64654, Q8K0C4 | |
| Cyp51, CYP51A1 | |
| Recombinant full length Human CYP51A1. | |
| 100 μL | |
| Primary | |
| Human, Mouse, Rat | |
| Antibody | |
| IgG |
Corrección del contenido de un producto
Proporcione sus comentarios sobre el contenido del producto rellenando el siguiente formulario.
Título del producto
¿Detecta una oportunidad de mejora?Comparta una corrección de contenido